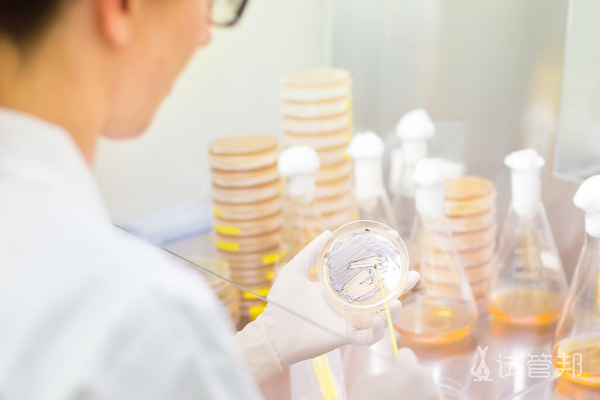
7cdbc1de49111c47b35f84cb71190bf9.png 男性生精质量需要做什么检查

男性如何提高生精质量和数量?男性生精质量的检测方法有哪些?是众多关注生殖健康的男性所关心的问题。通过一系列的生活调理和医学手段,男性可以有效提升精子的品質和數量。同時,借助專業的醫學檢測方法,男性也能及時瞭解自己的精子狀況,为生育健康打下坚实基础。
男性生精质量该怎么提高?
1.保持均衡饮食:摄入富含维生素C、锌、硒的水果、蔬菜和坚果,有助于精子健康。
2.控制体重:保持健康体重,避免肥胖或过瘦影響精子品質。
3.戒煙限酒:煙酒對精子不利,戒煙並限制酒精攝入有助於改善精子健康。
4.減輕壓力:長期壓力可能降低精子品質,採取放鬆、運動、冥想等方法应对压力。
5.适量运动:适度锻炼促进血液循环和体重管理,避免过度运动对精子健康的负面影响。

男性生精质量需要做什么检查?
1.精液分析:用于评估精子数量、活力和形态等,通常在禁欲2-7天后采样送检。
2.激素测定:通过血液样本检查激素水平,帮助识别内分泌异常对精子产生的影响。
3.睾丸超声:检查睾丸是否有肿块或其他不育问题,使用高頻聲波掃描陰囊區域。
4.染色體分析:通過抽血分析DNA結構,確定是否有遺傳異常導致不育。
5.输精管造影术:通过注射造影剂并拍X光,检查射精管道是否通畅及是否有堵塞。
男性生精质量受哪些因素影响?
1.不良生活习惯:长期吸烟、饮酒或熬夜可能导致精子质量下降,应避免这些习惯,保持健康生活方式和充足睡眠。
2.慢性疾病:如前列腺炎、精囊炎等慢性疾病可能影响精子质量,建議積極治療原發病。前列腺炎可用塞來昔布、阿奇黴素等藥物治療;精囊炎可使用頭孢呋辛鈉、左氧氟沙星等药物。
3.药物因素:长期使用某些抗生素如阿莫西林、頭孢克肟等可能影響精子品質,建議停藥並更換其他藥物。
此外,染色體異常等因素也可能導致不育,建議及時就医。
以上就是对,男性如何提高生精质量和数量?男性生精质量的检测方法有哪些?相关回答。提高男性生精质量和数量需要综合多种方法,包括饮食调理、適當運動、規律作息等。而檢測男性生精品質則主要依靠專業的醫學手段,如精液分析、激素測定等。通过这些方法,男性可以及时了解自己的生育健康状况,并采取相应的措施进行改善。
